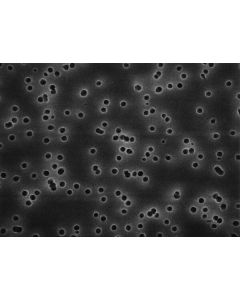
HTTP01300.jpg

The store will not work correctly when cookies are disabled.

MEMB. FILTRAÇÃO POLICARBONATO ISOPORE DIAM. 47mm PORO 0,22um LISA MILLIPORE (CX/100)
Modelo: GTBP04700
R$ 2.664,06

GAXETA EM TEFLON PARA SUPORTE MILLIPORE - 05 UND
Modelo: XX4004714
R$ 412,69

KIT PEÇAS REPOSICAO PARA SUPORTE 47 MM MILLIPORE - UND
Modelo: XX40047RK
R$ 3.108,22

MEMB. FILTRANTE POLICARBONATO ISOPORE DIAM. 13mm PORO 0,4um HIDROF. MILLIPORE (CX/100 UND)
Modelo: HTTP01300
R$ 530,17

MEMB. FILTRANTE PTFE OMNIPORE DIAM. 13mm PORO 0,22um MILLIPORE (CX/100 UND)
Modelo: JGWP01300
R$ 1.488,70

MEMB. FILTRANTE PTFE OMNIPORE DIAM. 47mm PORO 0,10um MILLIPORE (CX/100 UND)
Modelo: JVWP04700
R$ 1.609,07

MEMB. FILTRANTE PTFE OMNIPORE DIAM. 143mm PORO 0,1um MILLIPORE (CX/25 UND)
Modelo: JVWP14225
R$ 2.285,46

ANEL EM VITON P/ SUPORTE EM PP TIPO IN LINE DIAM. 47mm MILLIPORE - 06 UND
Modelo: XX4304702
R$ 383,96

KIT LIMITADOR DE FLUXO EM ACO INOX DIAM. 10 mm ( P/ 2.0, 3.0, 4.9, 10.0 E 14 L/miin) MILLIPORE
Modelo: XX5000000
R$ 3.169,60

GUIA COLORIMETRICO PARA FLUIDOS NAVAIS MILLIPORE
Modelo: XX6504713
R$ 1.635,08

ADAPTADOR PARA CONEXAO MONITOR PARA MANGUEIRA DE 3/16 MILLIPORE - 10 UND
Modelo: XX6200005
R$ 190,67

CONEXAO RAPIDA 1/4 EM ACO INOX MILLIPORE - UND
Modelo: XX6700030
R$ 1.330,48